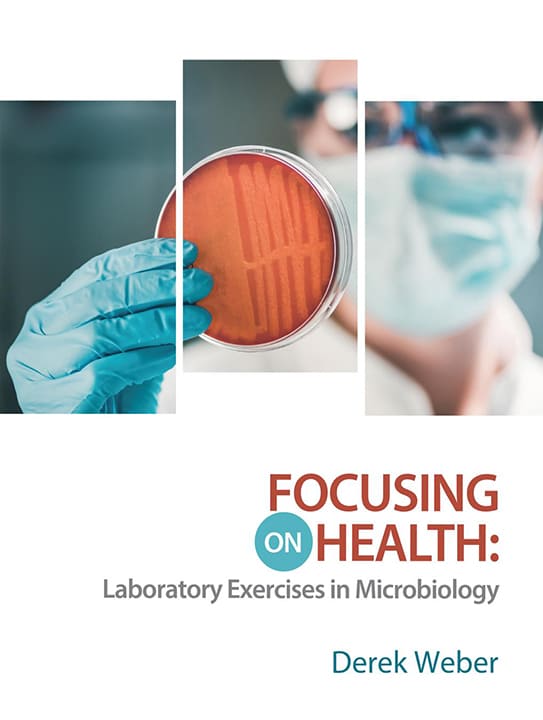
Cover of Focusing on Health: Laboratory Exercises in Microbiology

Top Hat with Interactive eText
-
1
Make complex concepts digestible with dynamic questions, interactive diagrams, animations, and video demonstrations
-
2
Edit text, embed videos, and add or create supplemental resources to keep your lab manual up-to-date
-
3
Incorporate pre-lab assessments to get immediate insights into comprehension and make the most of your time with students